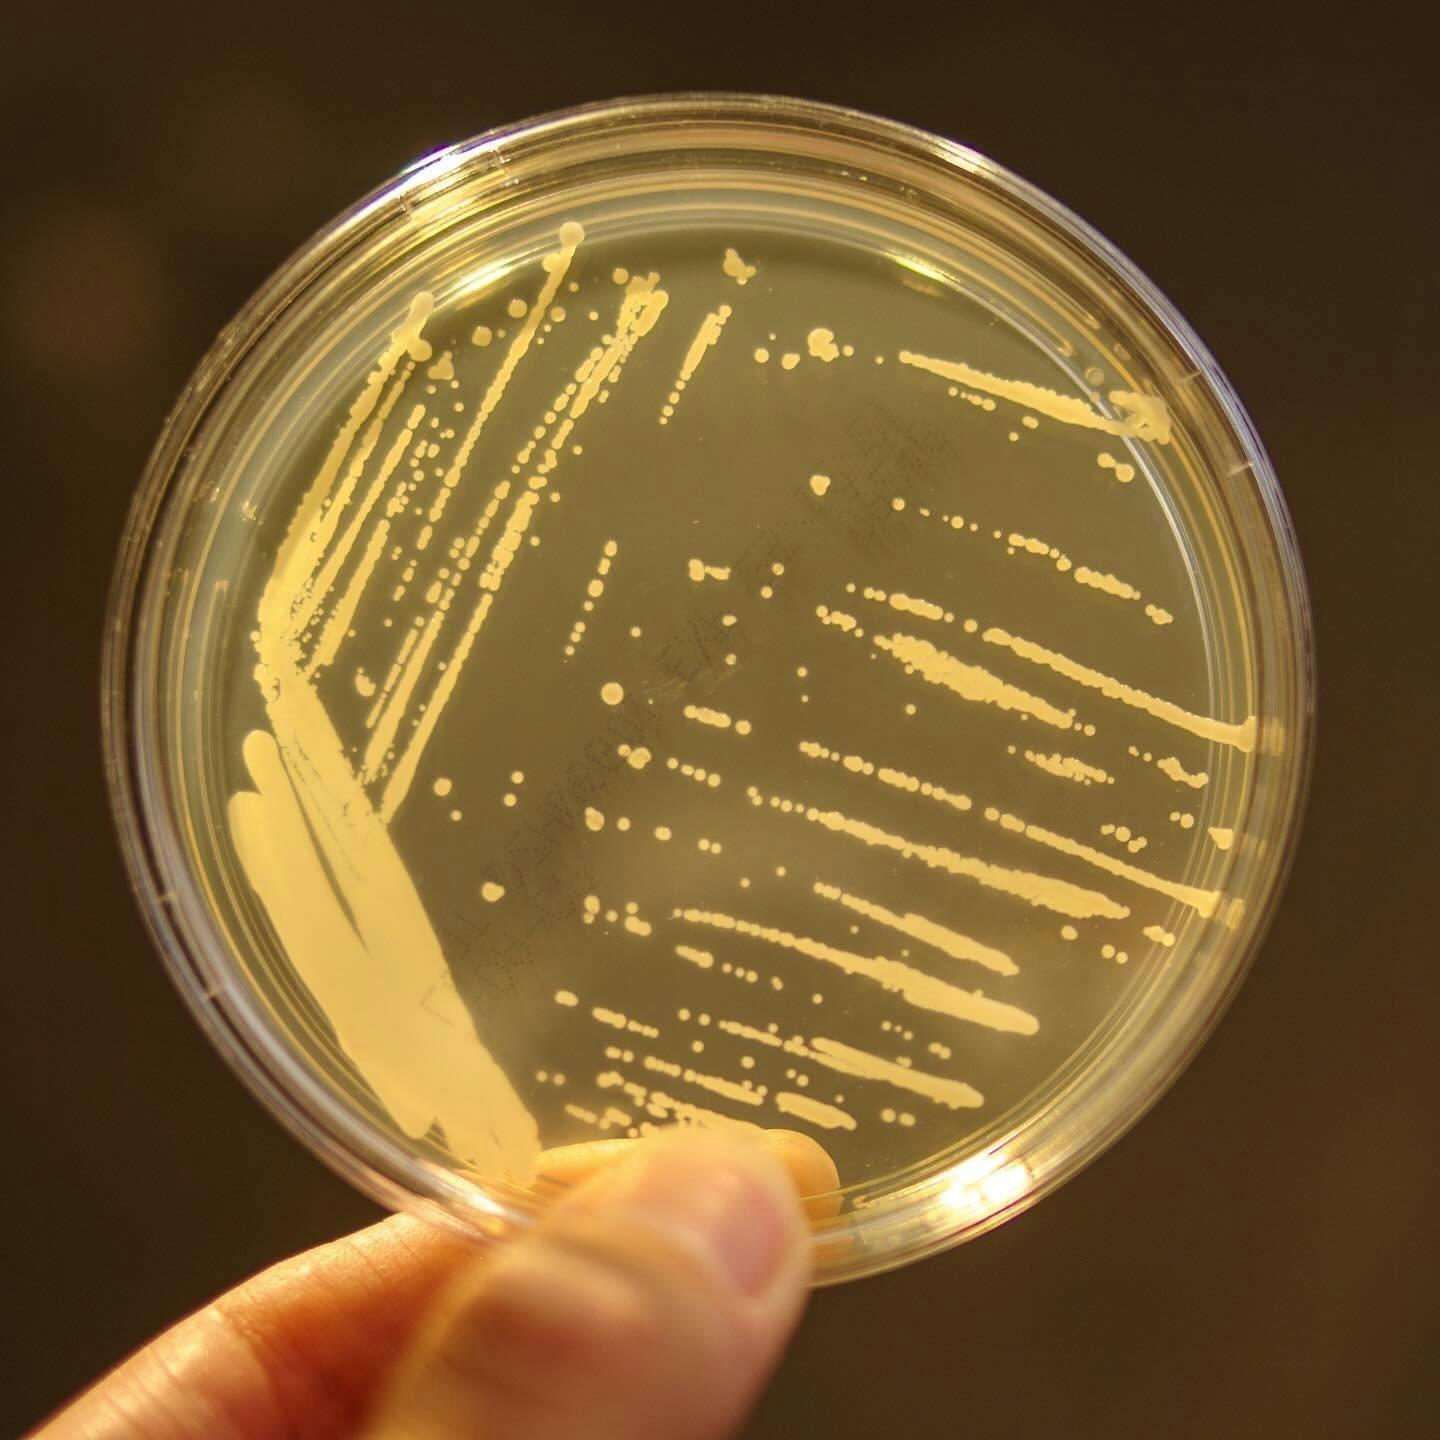

みなさま、こんにちは。Cultiva代表の副田大介(そえだ だいすけ)です。
今回は、私たちが取り組んでいる「野生酵母」の挑戦についてご紹介します。
みなさまは「蔵付き酵母」をご存じでしょうか。
その名のとおり、酒蔵に住み着いた酵母のことで、蔵での仕込みが代々積み重なることで独自に形成されるものです。酵母を意図的に添加しなくても自然に発酵が進むため、昔ながらの酒蔵ではこの蔵付き酵母を頼りに酒造りが行われてきました。現在は、日本醸造協会が頒布する「協会酵母」を添加するのが一般的ですが、蔵付き酵母には造り手なら誰しも憧れを抱くものです。

とはいえ、できたばかりの私たちの醸造所で蔵付き酵母を期待するのは現実的ではありません。そこで試みたのが、醸造所の環境から「野生酵母」を単離する試みでした。そやし水(生米と炊いた米を混ぜた水)に乳酸菌を繁殖させ、意図的に酸性にした環境に米麹を加え、自然と酵母が湧きつくのを待ったのです。こうして発見されたのが、Cultiva糸島醸造所の環境から生まれた、穏やかな香りを持つ野生酵母です。
私たちがこの野生酵母を使う理由は、主に2つあります。
1. その土地に根付いた酵母を使うことで、唯一無二の酒を醸したい。
2. 協会酵母が「低温」で安定した発酵を得意とするのに対し、野生酵母は「比較的高い温度」でなければ発酵が進みません。そのため麹の酵素が活発に働き、米がよく溶け、どぶろくの甘みや旨みに変換されやすくなるのです。
つまり、協会酵母が「低温発酵」を強みにしているのに対し、野生酵母は「高温発酵」を特徴とし、米の旨みを引き出す力を持っているのです。また、協会酵母が出すような華やかな香りを抑えられる分、米本来の味を感じやすいのではないかとも考えています。
もちろん、無添加で自然発酵に任せる造りにはリスクも伴います。だからこそ私たちは「安定性」と「独自性」の両立を目指し、この野生酵母を添加することで米の味をさらに引き出そうとしています。
もしこの酵母が蔵に定着すれば、真の意味で「蔵付き酵母のどぶろく」を実現できる日が訪れるかもしれません。その日を目指し、Cultivaはこれからも挑戦を続けていきます。











